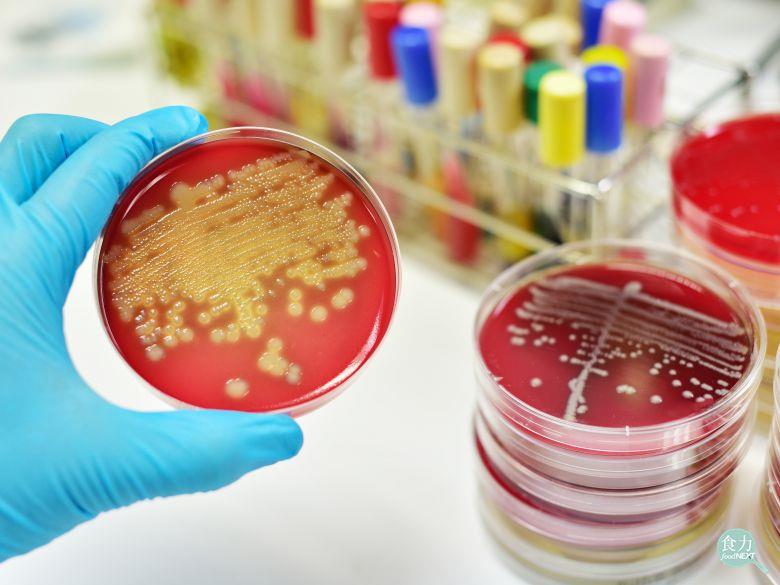

你應該要知道的食事
食品最常被檢驗的項目之一就是大腸桿菌與大腸桿菌群,這2者經常存在於糞便中並污染水源,因此若是食物中被驗出這2者含量超標,就代表在食物生產製造的過程中,有處理不當導致污染的疑慮。
撰文=黃宜稜
2017年2月22日,台中市衛生局公布日前抽驗餐飲業的壽司,總計32件,其中初驗不符合衛生標準的有8件,爾後經複查仍有1件不合格,即為知名餐飲業者「響食天堂」販售的花壽司。此事件引起軒然大波,同時也引起許多民眾的疑問,為什麼要抽驗大腸桿菌呢?大腸桿菌真的有那麼可怕嗎?
大腸桿菌(Escherichia coli,簡稱E.coli)為一種革蘭氏陰性短桿菌,普遍存在於人類與溫血動物的腸道中,也因此會隨著糞便排出,一般來說只有少數的病原性大腸桿菌會引發腸道感染或食物中毒等問題。
除了抽驗大腸桿菌之外,經常會聽到抽驗大腸桿菌群(Coliform),可別以為這是指「一群大腸桿菌」,其實大腸桿菌群是指大腸桿菌、檸檬酸桿菌(Citrobacter)、克雷白氏菌(Klebsiella)及腸桿菌(Enterobacter)等菌屬,大量存在於人類與溫血動物的糞便中,以及人類經常活動的場所。
其實大腸桿菌與大腸桿菌群都不耐熱,只要將食物加熱煮熟即可,因此最常聽到被驗出大腸桿菌的食物通常是生食,例如生乳、生魚片、果汁或是其他遭到生食污染的食物,然而為什麼要特別抽驗大腸桿菌呢?
那是因為細菌的種類非常多樣,常見的如沙門氏菌、金黃色葡萄球菌、仙人掌菌等,若要一項一項抽驗實在太耗費時間與金錢了,而大腸桿菌與大腸桿菌群經常存在於糞便中並污染水源,因此若是食物中被驗出這2者含量超標,就代表在食物生產製造的過程中,有處理不當導致污染的疑慮,例如生食熟食交叉感染、生水未煮沸等等,此外相對於其他細菌,這2者的檢驗方法與費用也較簡單。

延伸閱讀:
▶想喝路邊攤的現榨果汁?小心細菌一起喝下肚!!!
▶加拿大將允許販售輻照牛絞肉 以降低食源性疾病風險
▶為什麼市場攤販熟食肉品驗菌不合格比率高?